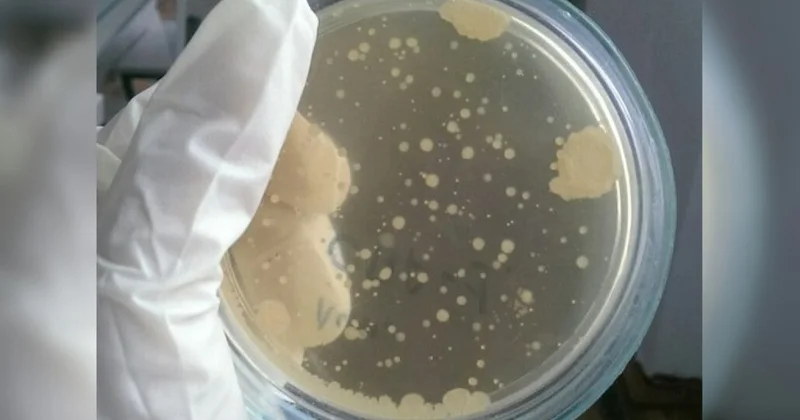
И свой, и умный

Учёные подтвердили, что выброс плазмы на Солнце направлен в сторону Земли
По информации сайта Informburo.KZ, передает Qazaq24.com.
Первые данные, полученные с космических коронографов, подтвердили факт фронтального коронального выброса, направленного вдоль линии Солнце – Земля с отклонением примерно на 20° к северу, пишет Лаборатория солнечной астрономии ИКИ РАН.
На снимках выброс выглядит как расширяющееся облако плазмы, движущееся в сторону наблюдателя.
"Основная масса вещества сосредоточена в данный момент в верхней части плазменного облака; особенно высокая концентрация газа наблюдается на северо-востоке (слева сверху), где вспышкой был разрушен крупный протуберанец, остатки которого частично всё же попали в межпланетное пространство", – говорится в сообщении
В нижней части выброса преобладают уплотнённые магнитные поля при относительно низком содержании вещества.
Учёные отмечают значительную неравномерность структуры облака, что пока не позволяет точно определить параметры выброса. Ожидается, что в ближайшие часы поступят новые данные и первые расчётные модели.
Другие новости на эту тему:
Просмотров:86
Эта новость заархивирована с источника 09 Ноября 2025 21:04 



Войти
Новости
Погода
Магнитные бури
Время намаза
Драгоценные металлы
Конвертор валют
Кредитный калькулятор
Курс криптовалют
Гороскоп
Вопрос - Ответ
Проверьте скорость интернета
Радио Казахстана
Казахстанское телевидение
О нас








Самые читаемые